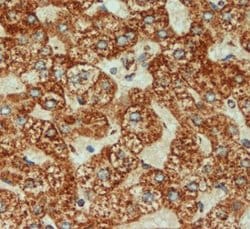
Invitrogen COX4 Polyclonal Antibody 100 &mu;g; Unconjugated:Antibodies,

Learn More
Invitrogen™ COX4 Polyclonal Antibody


Rabbit Polyclonal Antibody
Brand: Invitrogen™ PA519471
Description
Heat mediated antigen retrieval recommended prior to tissue staining. This antibody is predicted to react with chimpanzee based on sequence homology. Store antibody at 4°C for 1-2 weeks. For long-term storage, store at -20°C.
Cytochrome c oxidase (COX) is the terminal enzyme of the mitochondrial respiratory chain. It is a multi-subunit enzyme complex that couples the transfer of electrons from cytochrome c to molecular oxygen and contributes to a proton electrochemical gradient across the inner mitochondrial membrane. The complex consists of 13 mitochondrial- and nuclear-encoded subunits. The functions of the nuclear-encoded subunits are unknown but they may play a role in the regulation and assembly of the complex. COX4 (COX4I1) is one of the nuclear-coded polypeptide chains of cytochrome c oxidase, the terminal oxidase in mitochondrial electron transport.
Specifications
| COX4 | |
| Polyclonal | |
| Unconjugated | |
| COX4I1 | |
| AL024441; C16orf2; C16orf4; COX; cox iv; COX IV-1; Cox IV-2; Cox4; COX4 neighbor; Cox4-1; COX4-2; Cox4a; COX4AL; Cox4b; COX4I1; cox4i1.S; Cox4i2; COX4L2; COX4NB; coxiv; COXIV-1; CoxIV-2; cytochrome c oxidase polypeptide IV; Cytochrome c oxidase subunit 4 isoform 1, mitochondrial; cytochrome c oxidase subunit 4 isoform 2, mitochondrial; cytochrome c oxidase subunit 4I1; cytochrome c oxidase subunit 4I2; cytochrome c oxidase subunit IV; cytochrome c oxidase subunit IV isoform 1; cytochrome c oxidase subunit IV isoform 1 precursor; cytochrome c oxidase subunit IV isoform 1 S homeolog; cytochrome c oxidase subunit IV isoform 2; cytochrome c oxidase subunit IV isoform 2 (lung); cytochrome c oxidase subunit IV precursor EC 1.9.3.1; cytochrome c oxidase subunit IV-like 2; cytochrome c oxidase, subunit 4a; cytochrome c oxidase, subunit 4b; cytochrome c oxidase, subunit IV; cytochrome c oxidase, subunit IVa; cytochrome c oxidase, subunit IVb; cytochrome c oxydase subunit 4; dJ857M17.2; EMC8; ER membrane protein complex subunit 8; FAM158B; family with sequence similarity 158, member B; FLJ23483; hypothetical protein MGC73355; IV-1; mg:bb02d03; MGC72016; Neighbor of COX4; NOC4; Protein FAM158B; XELAEV_18024950mg; zgc:110058; zgc:73355 | |
| Rabbit | |
| Antigen affinity chromatography | |
| RUO | |
| 12857, 1327, 29445 | |
| Store at 4°C short term. For long term storage, store at -20°C, avoiding freeze/thaw cycles. | |
| Liquid |
| Immunohistochemistry (Paraffin), Western Blot, Immunocytochemistry | |
| 0.8 mg/mL | |
| PBS with 1% BSA and 0.02% sodium azide; pH 7.4 | |
| P10888, P13073, P19783 | |
| COX4I1 | |
| Synthetic peptide conjugated to KLH derived from within residues 150 to the C-terminus of Human COX IV. | |
| 100 μg | |
| Primary | |
| Human, Mouse, Rat | |
| Antibody | |
| IgG |
Your input is important to us. Please complete this form to provide feedback related to the content on this product.